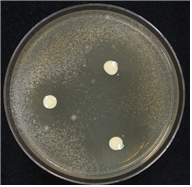

|
사일리지(담근먹이)는 수분함량이 많은(60~65%) 조사료 조사료: 지방, 단백질, 전분 등의 함량이 적고 섬유질이 18% 이상 되는 사료, 청초, 건초 따위
를 공기가 불충분한 상태에서 젖산발효시킨 것으로, 부패균의 번식을 억제해 생초의 양분 손실은 적고 저장성은 높다.
고섬유질로 되새김질하는 반추위가축에 적합하며, 돼지와 닭 등의 단위동물에게 줄 경우에는 생산성 및 영양소 소화율이 감소한다고 알려져 있다.
그러나 돼지나 닭에게 사일리지를 줄 경우 사료비 절감, 장내 유익균 성장, 스트레스 감소 등의 장점도 있어 사일리지 이용성 향상을 위한 연구가 계속돼 왔다.
농촌진흥청은 돼지와 닭을 위한 총체맥류 사일리지 제조용 미생물 균주를 개발했다.
보리, 밀 등의 총체맥류 사일리지는 알곡이 30~40% 포함돼 사료가치가 우수하며, 겨울 동안의 휴경지를 이용해 재배할 수 있다는 장점이 있다.
이번에 개발한 균주는 산생성능 및 항균 작용이 우수한 유산균 ‘락토바실러스 5-1 (Lactobacillus sp. 5-1) 균주’와 섬유소 분해능이 우수한 혐기성 세균 ‘셀룰로실라이티쿰 WCF-2 (Cellulosilyticum sp. WCF-2) 균주’로 각각 사일리지와 쇠똥에서 분리했다.
두 미생물 균주를 접종해 총체맥류 사일리지를 제조할 경우, 접종하지 않은 경우에 비해 사일리지의 산도가 빠르게 증가해 부패균의 성장을 낮추는 효과가 있다.
두 미생물 균주를 접종해 제조한 총체맥류 사일리지로 배합사료의 10%를 대체한 후 비육돈 비육돈: 질 좋은 고기를 많이 내기 위해 특별한 방법으로 살이 찌도록 기르는 돼지에게 줬을 때, 하루 동안 증가된 체중의 평균치, 건물소화율 및 단백질 이용성은 배합사료와 차이가 없었다.
또한 두 미생물 균주를 접종해 제조한 총체맥류 사일리지를 5~20%까지 혼합해 산란계에 줬을 때, 일반 사료를 먹은 대조구에 비해 산란율과 달걀이 깨지는 비율(파란율)은 차이가 없었다.
농촌진흥청은 이번에 개발한 총체맥류 사일리지 발효제에 대해 특허출원(10-2017-0144461)을 완료하고, 미생물제제 생산기술 개발 후 축산 농가에 보급할 계획이다.
농촌진흥청 농업미생물과 안재형 농업연구사는 “유산균과 섬유소 분해균을 첨가해 총체맥류 사일리지의 보존성은 증가하고, 돼지와 닭에 대한 소화율이 향상돼 국내산 풀사료 이용률을 높일 수 있을 것으로 기대한다.”라고 말했다.